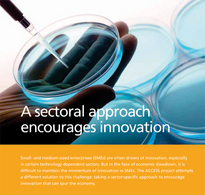

Central Projects
We currently support 124 projects in six thematic fields. Our database provides you with detailed information on each project.
CENTRAL EVENTS

CENTRAL EUROPE
CENTRAL EUROPE is a European Union programme that encourages cooperation among regions of nine central European countries: Austria, Czech Republic, Germany, Hungary, Italy, Poland, Slovakia, Slovenia and Ukraine. It aims to improve innovation, accessibility and the environment and to enhance the competitiveness and attractiveness of their cities and regions.